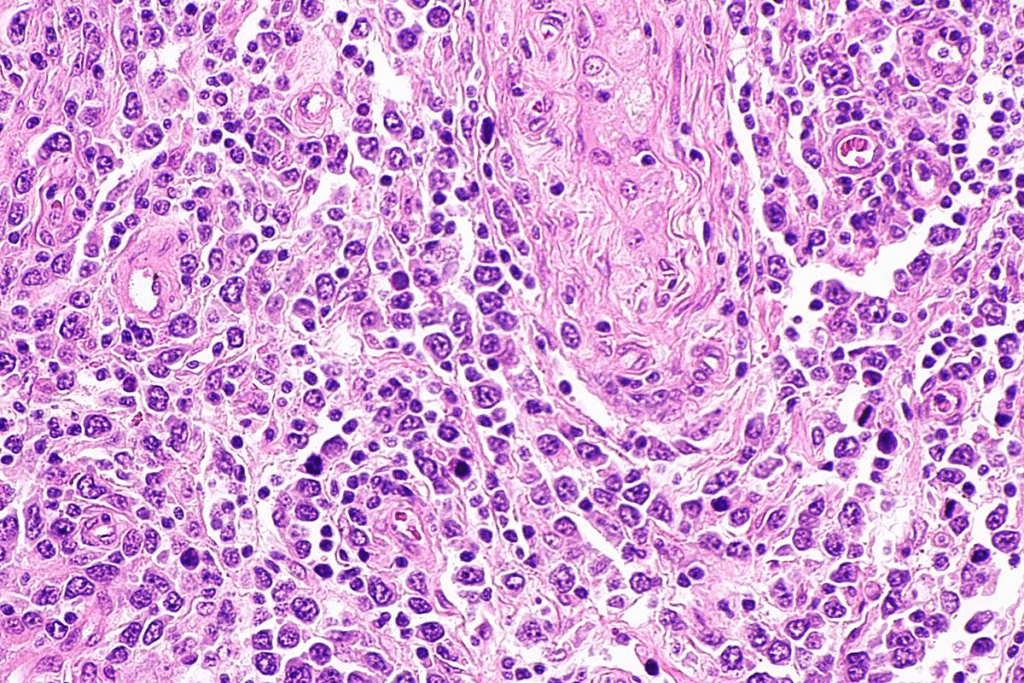
Adenomyosis Stage 4: Is It Dangerous?

We’re here to explain adenomyosis stage 4. It’s a condition where endometrial tissue grows into the uterine wall. This causes severe symptoms.
This condition can lead to heavy menstrual bleeding, severe pelvic pain, and painful intercourse. These symptoms can really affect your life. Knowing if adenomyosis is cancerous or not is key for the right treatment.
We’ll look into the signs of this serious gynecological issue and what makes it different.
Key Takeaways
- Stage 4 adenomyosis is the most severe form of adenomyosis.
- It is characterized by the extensive infiltration of endometrial tissue into the uterine myometrium.
- Symptoms include heavy menstrual bleeding, severe pelvic pain, and painful intercourse.
- Adenomyosis is a benign condition, not cancerous.
- Advanced imaging is critical for diagnosing stage 4 adenomyosis.
Understanding Adenomyosis: Definition and Prevalence

Adenomyosis is a gynecological disorder. It happens when tissue like the lining of the uterus grows into the muscular wall of the uterus. This condition causes a lot of discomfort and health problems for women.
What is Adenomyosis?
Adenomyosis is when endometrial tissue, which lines the uterus, grows into the myometrium. This can cause heavy menstrual bleeding and pelvic pain. It really affects a woman’s life quality.
How Common is Adenomyosis?
About one in five women get adenomyosis during their reproductive years. Studies show that around 20% of women are affected.
Age Groups Most Affected
Women between 30 and 50 years old are most affected by adenomyosis. This age range is key because it’s when women are most active in their reproductive years.
Causes and Risk Factors for Developing Adenomyosis

It’s important to know what causes adenomyosis to catch it early. While we don’t know the exact cause, research has found several factors that play a role.
Hormonal Influences
Hormones, like estrogen, are key in adenomyosis. Estrogen makes endometrial tissue grow, which is a big part of adenomyosis. This is why it often happens in women of childbearing age.
Genetic Predisposition
Genetics might also play a part in adenomyosis. Women with a family history of it or similar conditions might be more at risk. More research is needed to understand the genetic side of adenomyosis.
Prior Uterine Surgery
Having had uterine surgery, like a C-section or myomectomy, can increase adenomyosis risk. Surgery can cause endometrial tissue to grow into the myometrium, leading to adenomyosis.
Relationship to Childbirth
Childbirth is also a risk factor for adenomyosis. It can cause endometrial tissue to grow into the uterine wall. Women who have had multiple births might be at higher risk because of repeated uterine stretching and possible trauma.
Knowing these risk factors helps doctors spot women who might get adenomyosis. This can lead to earlier diagnosis and treatment.
The Progression of Adenomyosis: From Stage 1 to Stage 4
Adenomyosis goes through four stages. Each stage shows how deep endometrial tissue gets into the uterine wall. This matters because it shows how bad the symptoms are and how it affects a person’s life.
Overview of Adenomyosis Staging
Doctors use stages to understand how bad adenomyosis is. They look at how much endometrial tissue is in the myometrium, the muscle layer of the uterus. This helps them decide the best treatment.
Characteristics of Each Stage
Adenomyosis changes a lot as it goes from Stage 1 to Stage 4.
Stage 1 is the start, with little endometrial tissue in the myometrium.
Stage 2 shows more tissue invasion, covering a bigger part of the myometrium.
Stage 3 means the tissue has invaded deeply, changing the shape of the uterus.
Stage 4 is the worst, with tissue all through the myometrium. The uterus gets very big and misshapen.
Stage | Characteristics | Uterine Involvement |
Stage 1 | Minimal invasion | Limited to the inner myometrium |
Stage 2 | More pronounced invasion | Affects a larger area of the myometrium |
Stage 3 | Significant infiltration | Potential distortion of uterine architecture |
Stage 4 | Complete infiltration | Substantial uterine enlargement and distortion |
How Stage 4 Differs from Earlier Stages
Stage 4 adenomyosis is very different from earlier stages.
The uterus gets very big because of the tissue invasion. People with Stage 4 often have very heavy periods and pain in the pelvis.
Knowing these differences helps doctors and patients plan the best treatment.
Adenomyosis Stage 4: Complete Myometrial Infiltration
Adenomyosis Stage 4 means the uterine wall is fully covered with endometrial tissue. This causes big changes in the uterus. It can really hurt a woman’s quality of life.
Defining Stage 4 Adenomyosis
Stage 4 adenomyosis is when endometrial tissue fills the uterine myometrium. This makes the uterine wall thick and big. It can also change the shape of the uterus.
Doctors say a woman has Stage 4 adenomyosis if the endometrial tissue covers more than 80% of the myometrium. This can make the uterus grow very big, like a large grapefruit.
Pathophysiology of Advanced Adenomyosis
Stage 4 adenomyosis happens when endometrial glands and stroma move into the uterine muscle. This messes up the normal uterine tissue. It leads to inflammation, scarring, and a big uterus.
The endometrial tissue grows into the myometrium and reacts to hormones. This causes bleeding in the uterine wall. It leads to more inflammation and damage.
Uterine Changes in Stage 4
In Stage 4 adenomyosis, the uterus changes a lot. These changes include:
- Uterus gets very big
- Uterine cavity shape changes
- Uterine walls get thick
- More blood flow and vascularity
- Adenomyomas might form
Uterine Changes | Characteristics | Clinical Implications |
Uterine Enlargement | Significant increase in uterine size | Pelvic pressure, discomfort |
Uterine Wall Thickening | Asymmetric or diffuse thickening | Menstrual irregularities, pain |
Cavity Distortion | Alteration of uterine cavity shape | Potential impact on fertility |
These changes can cause symptoms like heavy bleeding, severe pain, and pressure. Knowing about these changes helps manage Stage 4 adenomyosis better.
Clinical Symptoms of Stage 4 Adenomyosis
Stage 4 adenomyosis brings severe symptoms that greatly affect a woman’s life. These symptoms worsen over time, impacting both physical and emotional health.
Heavy Menstrual Bleeding (Menorrhagia)
Heavy menstrual bleeding, or menorrhagia, is a key symptom of Stage 4 adenomyosis. It leads to anemia, fatigue, and more. Women often need to change sanitary products often, disrupting their daily lives.
Managing menorrhagia is key to improving life quality. Treatments include hormonal therapies, tranexamic acid, or surgery to reduce bleeding.
Chronic Pelvic Pain and Pressure
Women with Stage 4 adenomyosis often experience chronic pelvic pain and pressure. The pain can be constant or worse during menstruation. This is due to endometrial tissue in the uterine muscle, causing inflammation.
The pressure can feel like a heavy sensation in the pelvis. Managing chronic pain is vital. Various treatments, like pain meds and alternative therapies, can help.
Painful Intercourse (Dyspareunia)
Painful intercourse, or dyspareunia, is common in Stage 4 adenomyosis. The pain is due to inflamed uterine tissues. This can harm intimate relationships and sexual health.
Addressing dyspareunia is important in treating Stage 4 adenomyosis. Treatment may include managing adenomyosis and counseling for emotional support.
Other Common Symptoms
Women with Stage 4 adenomyosis may also face:
- Bloating and discomfort in the lower abdomen
- Increased urinary frequency or urgency
- Constipation or painful bowel movements during menstruation
- Fatigue due to chronic pain and heavy bleeding
Each woman’s experience with Stage 4 adenomyosis is different. A treatment plan that addresses all symptoms is essential for better quality of life.
Diagnostic Imaging: What Stage 4 Adenomyosis Looks Like
Knowing what Stage 4 adenomyosis looks like on imaging is key for correct diagnosis and treatment. Ultrasound and MRI are vital for spotting this condition’s signs.
Ultrasound Findings
Ultrasound shows Stage 4 adenomyosis as thickened myometrium with unclear edges. Myometrial cysts are common, appearing as dark or light spots in the myometrium. The area between the endometrium and myometrium may also look thick and uneven.
Ultrasound is often the first choice because it’s easy to use and doesn’t hurt. But, how well it works can depend on the person using it.
MRI Characteristics
MRI gives a clearer view of adenomyosis, mainly in Stage 4. It shows how much of the myometrium is affected and how thick the junctional zone is. On MRI, adenomyosis looks dark on T2-weighted images. Myometrial cysts appear bright on T2-weighted images.
Imaging Modality | Characteristics of Stage 4 Adenomyosis |
Ultrasound | Diffuse myometrial thickening, indistinct borders, myometrial cysts |
MRI | Low-signal intensity on T2-weighted images, thickened junctional zone, myometrial cysts |
Other Diagnostic Methods
Ultrasound and MRI are the main tools, but hysteroscopy is also used. Hysteroscopy looks into the uterine cavity. It can spot issues like polyps or adhesions linked to adenomyosis.
In summary, imaging is critical for diagnosing Stage 4 adenomyosis. By knowing what to look for on ultrasound and MRI, doctors can accurately diagnose and plan treatments.
Is Adenomyosis Cancerous? Addressing Common Concerns
Many people wonder if adenomyosis is cancerous. Adenomyosis is when tissue inside the uterus grows outside of it, into the muscle walls. This can cause a lot of pain and heavy bleeding.
The Benign Nature of Adenomyosis
Adenomyosis is not cancer. It’s a benign condition. This means it’s not cancerous. The growth of tissue into the uterine wall is due to hormones and other factors, not cancer.
Differentiating Adenomyosis from Uterine Cancer
Adenomyosis and uterine cancer can have similar symptoms. These include heavy bleeding and pelvic pain. But, adenomyosis grows into the muscle, while cancer starts in the lining. Ultrasound and MRI help tell them apart.
Risk Factors for Malignancy in Adenomyosis Patients
Adenomyosis itself is not cancerous. But, some factors might raise the risk of cancer. These include family history of cancer, like endometrial or breast cancer. It’s important to talk to your doctor about your risk.
When to Seek Further Evaluation
If you have adenomyosis, watch for changes in symptoms or health. See your doctor if you notice unusual bleeding, severe pain, or other concerns. Regular check-ups are key to keeping an eye on your condition.
Adenomyosis vs. Endometriosis: Understanding the Differences
It’s important to know the differences between adenomyosis and endometriosis for the right treatment. Both involve endometrial tissue growing in the wrong place. But they affect women’s health in different ways.
Pathophysiological Comparison
Adenomyosis means endometrial tissue grows into the uterine wall. This makes the uterus thick and causes symptoms. On the other hand, endometriosis is when this tissue grows outside the uterus, often in the ovaries, fallopian tubes, and pelvic area.
This difference in where the tissue grows changes how each condition is treated and affects a woman’s life.
As a leading expert said, “The difference between adenomyosis and endometriosis is not just about where the tissue grows. It affects treatment and how well a woman can live.”
“Adenomyosis and endometriosis share some commonalities, but their differences are critical for clinicians to understand when developing treatment plans.”Medical Expert, Gynecologist
Symptom Similarities and Differences
Both adenomyosis and endometriosis can cause pelvic pain, heavy bleeding, and infertility. But adenomyosis often makes the uterus bigger and causes heavier bleeding. Endometriosis can lead to painful sex and problems with bowel or urinary functions if the tissue grows there.
Symptom | Adenomyosis | Endometriosis |
Pelvic Pain | Common, often chronic | Common, can be cyclic or chronic |
Heavy Menstrual Bleeding | Frequent, often severe | Possible, but not always present |
Infertility | Can be affected | Often associated |
Uterine Enlargement | Characteristic | Not typical |
Diagnostic Challenges
It’s hard to tell adenomyosis and endometriosis apart because their symptoms are similar. Doctors use imaging and surgery to make a diagnosis. Ultrasound and MRI help with adenomyosis, while laparoscopy is best for endometriosis.
Co-occurrence of Both Conditions
Many women have both adenomyosis and endometriosis. Research shows that a lot of women with adenomyosis also have endometriosis. This makes treatment more complex and requires a detailed plan.
Every woman’s experience with adenomyosis and endometriosis is unique. So, care needs to be tailored to fit each woman’s specific situation.
Treatment Options for Stage 4 Adenomyosis
Women with Stage 4 adenomyosis have several treatment options. These include medical management and surgical interventions. A mix of treatments is often needed to ease symptoms and improve life quality.
Medical Management Approaches
Medical management is usually the first step. Hormonal therapies like GnRH agonists and progestins are used. They help reduce bleeding and pain.
Surgical Interventions
When medical treatments don’t work, surgery is considered. Hysterectomy is a common choice for severe cases. Other options include endometrial ablation and uterine artery embolization.
Emerging Therapies
New treatments are being developed for Stage 4 adenomyosis. High-intensity focused ultrasound (HIFU) and magnetic resonance-guided focused ultrasound surgery (MRgFUS) are being studied.
Complementary and Lifestyle Approaches
Complementary therapies like diet changes and stress management help manage symptoms. Lifestyle changes, such as exercise and a healthy weight, also help.
Treatment Option | Description | Benefits |
Hormonal Therapies | GnRH agonists, progestins | Reduce bleeding, alleviate pain |
Hysterectomy | Surgical removal of the uterus | Definitive treatment for severe cases |
HIFU/MRgFUS | Minimally invasive ultrasound therapies | Non-invasive, preserves fertility |
Adenomyosis treatment is highly individualized.
A leading gynecologist notes, “Treatment for Stage 4 adenomyosis depends on symptoms, age, and fertility wishes.”
Living with Stage 4 Adenomyosis: Quality of Life and Fertility
Women with Stage 4 adenomyosis face big challenges. These affect their life quality, fertility, and mental health. It’s key to grasp how this condition impacts them in many ways.
Managing Chronic Pain
Chronic pain is a big problem for Stage 4 adenomyosis patients. It makes everyday tasks hard and lowers life quality. Effective pain management strategies are needed, like medicines, acupuncture, and physical therapy. “Pain is a complex issue that requires a multifaceted approach,” say experts in adenomyosis treatment.
Coping with Heavy Bleeding
Heavy menstrual bleeding from Stage 4 adenomyosis can cause anemia, fatigue, and make people feel isolated. To cope, women might try hormonal treatments, tranexamic acid, or surgery. It’s vital for women to discuss their symptoms openly with their healthcare provider to find the best treatment.
Impact on Fertility
The shape of the uterus in Stage 4 adenomyosis can make it hard to get pregnant. Adenomyosis itself doesn’t directly cause infertility, but it can make pregnancy harder. Women thinking about getting pregnant should talk to fertility specialists to understand their chances and risks.
Psychological Impact and Support Resources
Dealing with a chronic condition like Stage 4 adenomyosis can deeply affect mental health. It can lead to anxiety, depression, and feelings of loneliness.
“Support from healthcare providers, family, and support groups can make a significant difference in managing the emotional toll of adenomyosis.”
Getting help from mental health services and connecting with others who go through the same can really help.
Understanding how Stage 4 adenomyosis affects life quality and fertility helps us support those affected. It guides us in finding ways to improve their overall well-being.
Conclusion: Navigating a Stage 4 Adenomyosis Diagnosis
Getting a Stage 4 adenomyosis diagnosis can feel overwhelming. But knowing about the condition is the first step to managing it well. It’s important to understand adenomyosis fully.
Dealing with a Stage 4 adenomyosis diagnosis means knowing the condition, its symptoms, and treatment options. Being informed and proactive can greatly improve your life. We aim to provide top-notch healthcare and support to patients worldwide.
Knowing about Stage 4 adenomyosis and the help available helps you manage your diagnosis better. We suggest working closely with your doctor to find the right treatment for you.
By being proactive and informed, you can improve your health and deal with the challenges of Stage 4 adenomyosis. Managing this condition well is key to a better life.
Is Stage 4 adenomyosis cancerous?
No, Stage 4 adenomyosis is not cancerous. But, it’s important to tell it apart from uterine cancer. Both can have similar symptoms.
What are the symptoms of Stage 4 adenomyosis?
Symptoms include heavy bleeding during periods and chronic pelvic pain. You might also feel pain during sex and other symptoms that affect your life a lot.
How is Stage 4 adenomyosis diagnosed?
Doctors use ultrasound and MRI to diagnose it. These tests show the tissue growth in the uterus. Hysteroscopy might also be used.
What are the treatment options for Stage 4 adenomyosis?
Treatments include hormonal therapies and pain medications. Surgery like hysterectomy is also an option. There are new, less invasive treatments and lifestyle changes too.
How does adenomyosis differ from endometriosis?
Adenomyosis grows endometrial tissue into the uterus. Endometriosis grows outside the uterus. Though different, they can both cause similar symptoms.
Can adenomyosis affect fertility?
Yes, Stage 4 adenomyosis can affect fertility. The changed shape of the uterus might make it hard to get pregnant.
What is the prevalence of adenomyosis?
About 20% of women have adenomyosis. It mostly affects women between 30 and 50 years old.
Are there any risk factors for developing adenomyosis?
Yes, hormonal changes, uterine surgery, and childbirth can increase the risk. These factors can cause endometrial tissue to grow into the uterus.
How does Stage 4 adenomyosis impact quality of life?
Stage 4 adenomyosis can really affect your life. It causes chronic pain, heavy bleeding, and other symptoms. You need good care and support to manage it.
References
National Center for Biotechnology Information. Evidence-Based Medical Guidance. Retrieved from https://www.ncbi.nlm.nih.gov/pmc/articles/PMC8409806/